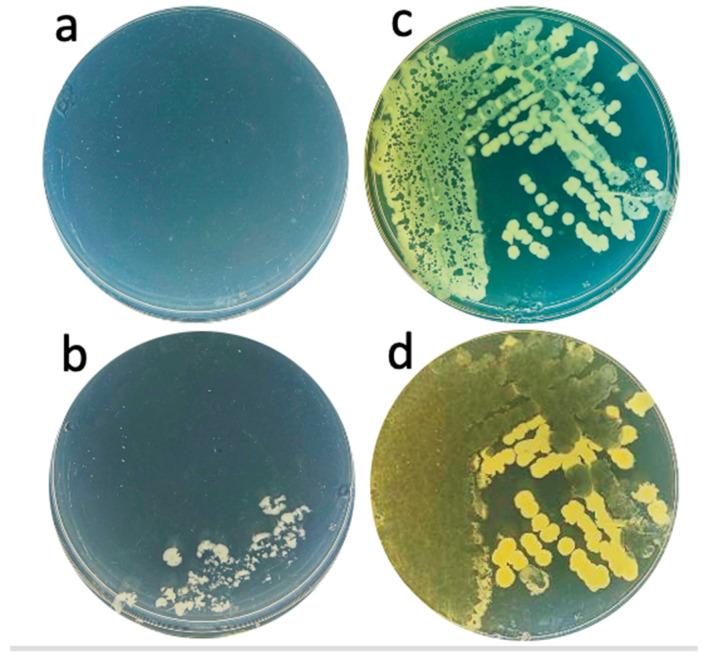
https://cdn.ncbi.nlm.nih.gov/pmc/blobs/7d34/11988461/624cde158d75/ijms-26-02914-g009.jpg
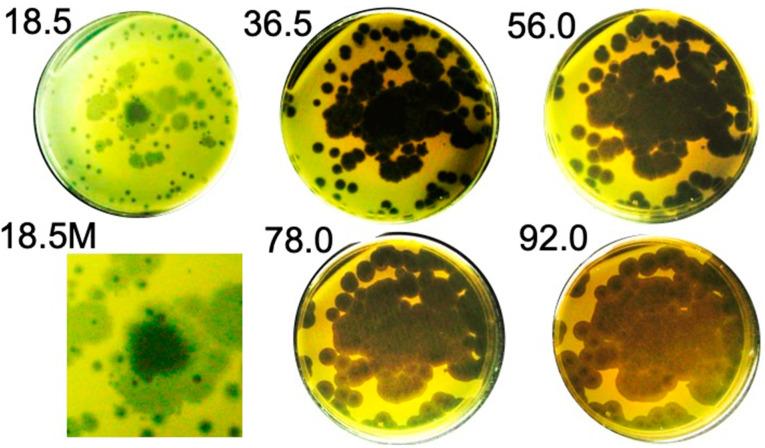
https://cdn.ncbi.nlm.nih.gov/pmc/blobs/7d34/11988461/b1a5f7b65d4a/ijms-26-02914-g003.jpg

绕过细菌对噬菌体的抗性进化:超攻击性噬菌体0524phi7-1的实例
Bypassing Evolution of Bacterial Resistance to Phages: The Example of Hyper-Aggressive Phage 0524phi7-1.
作者信息
Rojero Maria, Weaver-Rosen Meagan, Serwer Philip
机构信息
Department of Microbiology, Immunology and Molecular Genetics, UT Health, San Antonio, TX 78229, USA.
Department of Biochemistry and Structural Biology, UT Health, San Antonio, TX 78229, USA.
出版信息
Int J Mol Sci. 2025 Mar 23;26(7):2914. doi: 10.3390/ijms26072914.
The ideal bacteriophages (phages) for the treatment of bacterial disease (phage therapy) would bypass bacterial evolution to phage resistance. However, this feature (called a hyper-aggression feature) has never been observed to our knowledge. Here, we microbiologically characterize, fractionate, genomically classify, and perform electron microscopy of the newly isolated phage 0524phi7-1, which we find to have this hyper-aggression feature. Even visible bacterial colonies are cleared. Phage 0524phi7-1 also has three other features classified under hyper-aggression (four-feature-hyper-aggressive phage). (1) Phage 0524phi7-1 forms plaques that, although sometimes beginning as semi-turbid, eventually clear. (2) Clear plaques continue to enlarge for days. No phage-resistant bacteria are detected in cleared zones. (3) Plaques sometimes have smaller satellite plaques, even in gels so concentrated that the implied satellite-generating phage motion is not bacterial host generated. In addition, electron microscopy reveals that phage 0524phi7-1 (1) is a myophage with an isometric, 91 nm-head (diameter) and 210 nm-long contractile tail, and (2) undergoes extensive aggregation, which inhibits typical studies of phage physiology. The genome is linear double-stranded DNA, which, by sequencing, is 157.103 Kb long: family, ; genus, . The data suggest the hypothesis that phage 0524phi7-1 undergoes both swimming and hibernation. Techniques are implied for isolating better phages for phage therapy.
用于治疗细菌疾病的理想噬菌体(噬菌体疗法)应能避免细菌进化出对噬菌体的抗性。然而,据我们所知,这种特性(称为超侵袭特性)从未被观察到。在此,我们对新分离的噬菌体0524phi7 - 1进行了微生物学特性分析、分级分离、基因组分类,并进行了电子显微镜观察,发现它具有这种超侵袭特性。甚至可见的细菌菌落也会被清除。噬菌体0524phi7 - 1还具有归为超侵袭的其他三个特性(四特性超侵袭噬菌体)。(1)噬菌体0524phi7 - 1形成噬菌斑,虽然有时开始时是半透明的,但最终会变清。(2)清亮的噬菌斑会持续扩大数天。在清除区域未检测到抗噬菌体细菌。(3)噬菌斑有时会有较小的卫星噬菌斑,即使在凝胶浓度很高以至于暗示的产生卫星噬菌斑的噬菌体运动并非由细菌宿主产生的情况下也是如此。此外,电子显微镜显示噬菌体0524phi7 - 1(1)是一种肌尾噬菌体,头部呈等轴状,直径91nm,收缩尾长210nm,(2)会发生广泛聚集,这抑制了对噬菌体生理学的典型研究。基因组是线性双链DNA,经测序长157.103Kb:科, ;属, 。数据提出了噬菌体0524phi7 - 1既进行游动又进行休眠的假说。文中还暗示了用于分离更适合噬菌体疗法的噬菌体的技术。